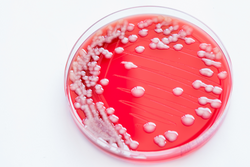
bacterial culture of Staphylococcus Colonies / bacteria gram negative bacilli./ Gram negative cocci bacilli on blood agar.

Research Topics in Microbiology
Microbiology explores microscopic organisms like bacteria, viruses, and fungi, studying their structure, function, and behavior. Using techniques like culturing and sequencing, our Research Topics unravel the complexities of microbial life and their impact on human health, agriculture, and the environment.
The following Research Topics are led by experts in their field and contribute to the scientific understanding of microbiology. These Research topics are published in the peer-reviewed journal Frontiers in Microbiology, as open access articles.
To begin your contribution, submit a manuscript summary to confirm fit with your chosen Research Topic before your full manuscript.